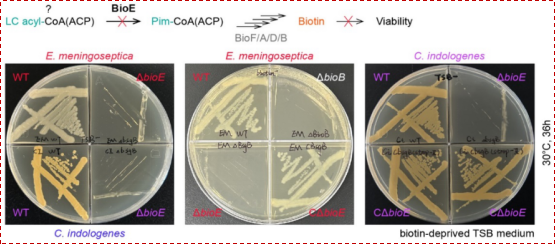
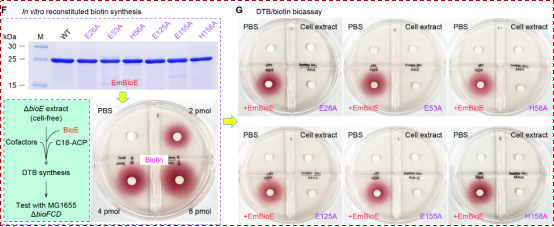

生物素(维生素 B7)是一种含硫的脂肪酸衍生物,作为辅酶参与脂肪酸合成等多种中心代谢过程。值得注意的是,部分病原菌能够通过自身合成或摄取生物素来增强其在宿主体内的定植与侵袭能力。因此,针对生物素代谢途径的研究正日益成为备受关注的潜在抗菌策略。生物素合成途径的“卡脖子”步骤是前体分子—庚二酸(pimelic acid)的生成。截止到目前,已发现了三条细菌来源的庚二酸生成途径:一是广泛存在的BioC–BioH路径,通过BioC对丙二酸单酰-CoA/ACP甲基化并劫持FAS II途径,随后由BioH去甲基化生成庚二酸单酰-ACP;二是限于芽孢杆菌科的BioI–BioW路径,P450样酶BioI切割长链酰基-ACP的C7–C8键产生庚二酸单酰-ACP,BioW 将外源庚二酸活化为庚二酸单酰-CoA;三是仅见于α-变形菌的BioZ路径,BioZ将赖氨酸分解产生的戊二酸单酰-CoA与丙二酸单酰-ACP缩合生成庚二酸单酰-ACP。
近年来,临床分离的伊丽莎白菌属(Elizabethkingia)常引起败血症和脑膜炎等院内获得性感染,且对多黏菌素及碳青霉烯类等“最后防线”抗生素表现出多重耐药性,传统抗菌策略一时之间捉襟见肘,亟需挖掘新靶点。基因簇分析显示,尽管这类细菌缺乏上述所有已知的庚二酸合成途径,它们仍能实现生物素的自主供给。这表明,伊丽莎白菌属中庚二酸的来源很可能涉及一种全新的生物素合成机制。

2025年12月4日,浙江大学基础医学院冯友军课题组在PNAS发表题为“A ferritin-like diiron oxygenase BioE initiates bacterial biotin synthesis, a promising anti-virulence target”的研究长文。该研究首次报道了自然界中可调节的第4条生物素从头合成通路—BioE-BioL途径,为封印耐药菌“生物素命门”的抗毒力药物研发提供了理论基础与新型靶标。
通过对KEGG数据库中涵盖2,034个属、共计8,890株细菌基因组的深入挖掘,研究团队在伊丽莎白菌/金黄杆菌的生物素操纵子(bioFDAB,负责生物素合成下游步骤)相邻区域发现了两个新型基因(图1):bioE(编码铁蛋白样/非血红素类/双铁加氧酶)和bioL(编码MocR型双功能转录因子)。

图1:生物素合成BioE-BioL新途径的挖掘
细菌遗传学结果表明:伊丽莎白菌ΔbioE敲除突变体是生物素营养缺陷型,而在该突变体中重新导入 bioE 基因,则可使其恢复为生物素原养型(图2)。这提示BioE蛋白确实参与了生物素的合成过程,但其具体作用的底物分子尚不明确。尽管BioE与蓝细菌醛脱甲酰加氧酶(cADO)的序列相似性仅为20%左右,但系统进化分析仍将其归为铁蛋白样/非血红素双铁加氧酶(FDO)这一蛋白质超家族。
图2:BioE的基因敲除可导致伊丽莎白/金黄杆菌呈现生物素营养缺陷型
通过结合分子筛层析与质量光度法,实验证实BioE以二聚体形式存在,且每个单体可能结合两个铁离子。该蛋白呈现出典型的“四螺旋束”结构,内部含有一条狭长的底物结合口袋。进一步的厌氧培养实验表明,BioE的催化功能严格依赖于氧气(图3)。基于结构的突变分析进一步表明,BioE 的六个关键残基(E26、E53、H56、E125、E155 和 H158)通过与铁离子相互作用,对维持BioE的功能具有关键作用(图3)。![]()

图3:BioE蛋白的生化表征
体外酶学实验表明,BioE蛋白具有独特的催化活性:它能识别长链脂酰基-CoA/ACP作为底物,通过四步连续反应——包括去饱和、双氧化、氧化切割以及醛氧化(共消耗10个电子)——在C7–C8键处发生氧化裂解,进而生成生物素前体分子庚二酸单酰-CoA/ACP,并释放长度为Cn-7的游离脂肪酸副产物(图4)。

图4:BioE的酶学反应模型
随后的化学生物学实验进一步夯实了BioE所介导的脂肪酸氧化切割反应:HPLC显示BioE可水解硬脂酰-CoA产生庚二酸单酰-CoA; GC/MS识别到甲基化产物为庚二酸二甲酯和十一烷酸甲酯;MALDI-TOF确认了硬脂酰-ACP可转化为庚二酸单酰-ACP。此外,基于伊丽莎白菌ΔbioE突变株的裂解液, 该研究建立了一套生物素体外合成系统,进一步明确了BioE在该合成途径中的关键作用(图5)。
![]() 图5:BioE启动生物素合成
图5:BioE启动生物素合成
从“遗传-生化-结构-感染”的四重维度,该研究对BioE功能进行了系统研究,成功发现其酶学催化与细菌毒力的关联。激光共聚焦成像实验表明:ΔbioE敲除可导致伊丽莎白/金黄杆菌生物膜形成能力大幅度丧失(图6); 体外免疫细胞实验表明:金黄杆菌ΔbioE突变株在小鼠骨髓来源巨噬细胞的胞内存活骤降; 动物感染模型中,BALB/c小鼠经腹腔感染ΔbioE突变株后致死率显著降低,血液及肝、脾、肾、肺等器官的菌载量下降,组织炎症与损伤程度明显减轻。上述结果支持BioE途径可视为潜在抗毒力药物靶点。

图6:BioE决定了伊丽莎白菌/金黄杆菌生物膜的形成
该研究成果破译了自然界中生物素合成的“第四条路线”,填补了Weeksellaceae科(如伊丽莎白菌、金黄杆菌)在庚二酸前体生成机制上的空白(图7)。此外,该研究拓展了铁蛋白样/非血红素类/双铁加氧酶(FDO)家族酶的催化多样性:不同于经典cADO的醛脱甲酰反应,BioE通过对长链脂肪酸进行氧化裂解直接生成C7前体,为FDO功能演化提供了新范式。![]()

图7:BioE代表了第四条生物素合成新途径
更为关键的是,BioE在哺乳动物中不存在同源蛋白,这意味着以其为靶点设计抑制剂,有望有效规避宿主毒性及常见的脱靶风险。此外,抑制BioE并非直接杀菌,而是通过切断细菌的生物素供应来削弱其致病力。这种作用模式避免了强烈的杀菌选择压力,符合“抗毒力”策略的核心思路。在临床应用中,若将BioE抑制剂与现有喹诺酮类抗生素(如环丙沙星、左氧氟沙星)联合使用,不仅可能提升疗效,也为应对多重耐药菌感染提供了新的潜在策略。
该研究获得了国家自然科学基金的耐药重点专项(32141001)与杰青项目(32125003)的共同资助,是冯友军课题组继发现ESKAPE耐药菌BioC生物素合成起始酶(Sci Adv, 2024)之后的又一力作。该课题组长期聚焦“耐药菌代谢与感染机制”,迄今为止发表研究论文100余篇,累计引用13100余次(h-index, 56),为抗菌靶点研发奠定了坚实基础。冯友军课题组出站博士后徐勇昌(现为杭州师范大学副教授)为该论文主要第一作者。浙江大学基础医学院冯友军教授、杭州师范大学徐勇昌副教授(出站博士后)、美国宾州州立大学 J. Martin Bollinger Jr. 讲席教授以及浙江大学医学院附属邵逸夫医院阮陟研究员为共同通讯作者。冯友军课题组诚邀志同道合的青年才俊,积极申请浙江大学“求是博士后”加盟该团队。



